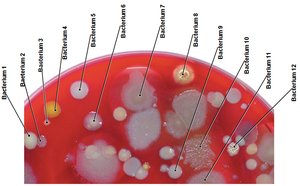
Agar plate

Back
BackChapter 1: A Brief History of Microbiology – Foundations, Classification, and Key Discoveries
Study Guide - Smart Notes

Chapter 1: A Brief History of Microbiology
The Early Years of Microbiology
Microbiology emerged as a scientific discipline through the study of microscopic organisms and their impact on health and the environment. Early scientists laid the foundation for understanding the unseen world.
Girolamo Fracastoro (1530): Proposed that epidemic diseases are caused by transferable tiny particles called "spores" or germs.
Robert Hooke (1665): Published Micrographia, describing minute bodies observed with magnifying glasses, marking the first use of microscopes in biology.


Development of Microscopy
The invention and improvement of microscopes enabled scientists to observe microorganisms, revolutionizing biology.
Antonie van Leeuwenhoek (1676): Created the first practical microscope and observed "animalcules" (microorganisms) in pond water, including bacteria and protozoa.
Microscope Evolution: From Leeuwenhoek's simple lens to modern compound microscopes, technological advances expanded our ability to study cells and microbes.



What Does Life Really Look Like?
Microorganisms display a wide range of forms and sizes, from bacteria to protozoa and algae. Microscopy reveals their diversity and complexity.
Observation: Leeuwenhoek's studies included algae, bacteria (rod-shaped), and protozoa (first animals).
Relative Sizes: Microbes range from nanometers (viruses) to micrometers (bacteria, protozoa), with some visible to the naked eye.


Classification of Microbes
Taxonomic Systems and Domains
Microorganisms are classified based on their cellular structure, genetic makeup, and evolutionary relationships. Carolus Linnaeus established the taxonomic system for naming and grouping organisms.
Six Categories: Bacteria, Archaea, Fungi, Protozoa, Algae, Small multicellular animals.
Domains: Eukarya (plants, animals, fungi, protists), Bacteria (eubacteria), Archaea (archaebacteria).

Prokaryotes vs. Eukaryotes
Microbes are divided into prokaryotes and eukaryotes based on cellular organization.
Prokaryotes: Unicellular, lack a true nucleus, reproduce asexually. Includes Bacteria (with peptidoglycan cell walls) and Archaea (cell walls lack peptidoglycan).
Eukaryotes: Uni- or multicellular, have a nucleus, reproduce sexually or asexually. Includes Fungi, Algae, Protozoa, and small multicellular animals.



Fungi
Fungi are eukaryotic organisms that obtain food from other organisms and have cell walls. They include multicellular molds and single-celled yeasts.
Molds: Multicellular, filamentous fungi.
Yeasts: Single-celled fungi, important in fermentation.

Algae
Algae are single-celled or multicellular eukaryotes, often capable of photosynthesis and locomotion. Some can cause disease.
Photosynthetic: Produce oxygen and serve as the base of aquatic food chains.


Protozoa
Protozoa are single-celled eukaryotes similar to animals in their nutritional needs and cellular structure. Most are motile and some are pathogenic.
Locomotion: Achieved via pseudopods, cilia, or flagella.
Pathogenicity: Some protozoa cause diseases in humans and animals.




Parasitic Worms
Parasitic worms (helminths) are studied in microbiology due to their microscopic life stages and impact on human health.
Range: From microscopic larvae to adult tapeworms several meters long.

Viruses
Viruses are acellular, obligatory parasites that require host cells to reproduce. They are much smaller than bacteria and are responsible for many diseases.
Structure: Consist of genetic material (DNA or RNA) surrounded by a protein coat.
Replication: Assemble inside host cells.

The Golden Age of Microbiology
Spontaneous Generation and Experimental Evidence
The theory of spontaneous generation (abiogenesis) proposed that living organisms could arise from nonliving matter. Experiments by Redi, Spallanzani, and Pasteur disproved this theory.
Redi's Experiment: Showed that maggots only develop in meat exposed to flies.
Spallanzani's Experiment: Demonstrated that microbes move through air and can be killed by boiling.
Pasteur's Experiment: Used swan-neck flasks to show that microbes come from outside, not spontaneously.



Germ Theory of Disease
The germ theory states that microorganisms are responsible for infectious diseases. This concept was developed through the work of Pasteur and Koch.
Pasteur: Demonstrated that microbes cause fermentation and disease.
Koch: Developed techniques for isolating, staining, and cultivating bacteria. Established Koch's postulates to prove causation of infectious diseases.


Advances in Microbial Techniques
New methods for culturing and identifying microbes were developed, including the use of agar and Gram staining.
Agar: Introduced by Fanny Hesse as a stable medium for culturing microbes.
Gram Stain: Developed by Christian Gram to differentiate bacteria based on cell wall structure.

Preventing Infection and Disease
Hygiene and Antiseptic Techniques
Improvements in hygiene and antiseptic practices greatly reduced infection rates in hospitals and communities.
Ignaz Semmelweis: Advocated handwashing to prevent healthcare-associated infections.
Joseph Lister: Introduced antisepsis using phenol and carbolic acid.
Florence Nightingale: Promoted hygiene and antiseptic techniques in hospitals.



Vaccination and Chemotherapy
Vaccination and the development of antimicrobial chemicals revolutionized disease prevention and treatment.
Edward Jenner: Developed vaccination using cowpox to prevent smallpox.
Paul Ehrlich: Pioneered chemotherapy, studying chemicals to destroy pathogens.


The Modern Age of Microbiology
Biochemistry and Metabolism
Biochemistry studies the chemical reactions (metabolism) that occur in living organisms. Discoveries in fermentation and enzyme activity revealed that biochemical reactions are shared by all living things.
Applications: Design of herbicides, diagnosis of illness, treatment of metabolic diseases, drug development.

Microbial Genetics and Molecular Biology
Microbial genetics explores inheritance in microorganisms. Molecular biology explains cell function at the molecular level, combining biochemistry, cell biology, and genetics.
DNA as Genetic Material: Avery–MacLeod–McCarty experiment demonstrated DNA's role in heredity.
Recombinant DNA Technology: Manipulation of genes for practical applications, including gene therapy.
Environmental Microbiology
Environmental microbiology studies the roles of microorganisms in natural environments, including biodegradation, recycling of elements, and water purification.
Biodegradation: Microbes break down dead organisms and recycle chemicals such as carbon, nitrogen, and sulfur.
Immunology and Disease Defense
Immunology is the study of the body's defense mechanisms against pathogens. Serum contains disease-fighting chemicals, and vaccines stimulate immunity.
Von Behring and Shibasaburo: Discovered serum therapy for disease treatment.
Future Directions in Microbiology
Microbiology continues to evolve, addressing challenges such as antimicrobial resistance, rapid diagnostics, and sustainable applications.
Control Programs: Tuberculosis, malaria, AIDS, Ebola.
Biofilms: Understanding microbial communities.
Bioremediation: Using microbes to clean up environmental pollutants.
Tables
Industrial Uses of Microbes
Microorganisms are used in various industrial processes, from food production to biotechnology.
Product or Process | Contribution of Microorganism |
|---|---|
Cheese | Flavoring and ripening by bacteria and fungi; depends on milk source and microbe type |
Alcoholic beverages | Alcohol produced by bacteria or yeast via fermentation of sugars |
Soy sauce | Produced by fungal fermentation of soybeans |
Vinegar | Produced by bacterial fermentation of sugar |
Yogurt | Produced by certain bacteria growing in milk |
Sour cream | Produced by bacteria growing in cream |
Artificial sweetener | Amino acids synthesized by bacteria |
Bread | Rising of dough by action of yeast; sourdough results from bacteria-produced acids |


Fields of Microbiology
Microbiology encompasses several disciplines, each focusing on different types of microbes or processes.
Discipline | Subject(s) of Study |
|---|---|
Bacteriology | Bacteria and archaea |
Phycology | Algae |
Mycology | Fungi |
Protozoology | Protozoa |
Parasitology | Parasitic protozoa and animals |
Virology | Viruses |
Microbial metabolism | Biochemistry; chemical reactions within cells |
Microbial genetics | Functions of DNA and RNA |
Environmental microbiology | Relationships between microbes and their environment |


Additional info: Where original content was brief, academic context was added to clarify definitions, historical significance, and practical applications. All images included are directly relevant to the adjacent paragraphs, reinforcing key concepts in microbiology.
